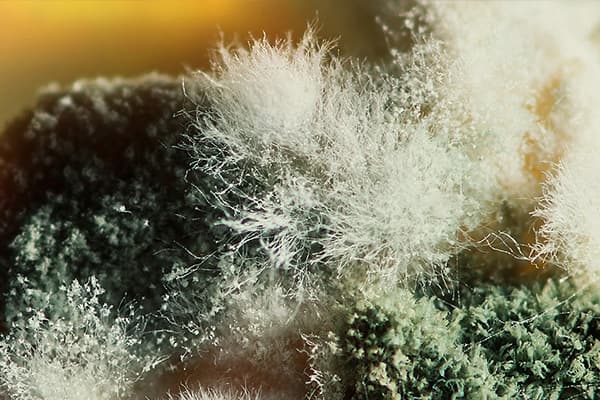
Moule près de

Quel est le danger d'apparition de moisissure dans l'appartement?
La moisissure n'est pas un invité rare dans nos maisons. Mais nous ne reconnaissons pas tous dans cet imposteur le danger qu’il représente réellement avec sa présence. Un revêtement tacheté noir est souvent perçu comme une saleté ordinaire. Et c’est bien si elle est même lavée périodiquement. En fait, tout n'est pas si simple et si inoffensif. Quel est le danger de moisissure dans l'appartement et pourquoi est-il nécessaire de s'en débarrasser?
Qu'est-ce que la moisissure?
La moisissure est un champignon. En conséquence, il a une micelle ("rhizome") à croissance rapide et se propage par des spores microscopiques. En présence de conditions favorables, les spores se développent rapidement sur tout matériau ou revêtement et commencent à se multiplier rapidement.
Où peut-on détecter des moisissures? Presque toutes les surfaces sont habitables pour les champignons:
- murs et plafond;
- fenêtres, miroirs;
- sol et portes;
- les meubles;
- tapis, vêtements;
- livres, papiers peints;
- appareils ménagers;
- plomberie, carrelage, tuyaux;
- matériaux de construction;
- produits.
C'est-à-dire qu'il peut vivre dans la cuisine, dans la salle de bain, dans les toilettes, dans le couloir, dans le garde-manger, dans la bibliothèque, dans le sous-sol ... Des matériaux relativement doux (bois, textiles, papier) de la colonie fongique peuvent provoquer un état de décomposition totale.
Même dans la chambre à coucher, si les conditions pour la vie du moule le permettent, il est capable de s'installer "sérieusement et de manière permanente". Et convient tout d’abord la chaleur, l’humidité et le manque de ventilation. Elle est toujours où humide, chaud et étouffant.
Les champignons de moisissure, comme tous les êtres vivants, sécrètent des produits métaboliques. Ce n'est que dans les moisissures que ces émanations sont toxiques. Une seule colonie de moisissures produit chaque jour des millions de spores microscopiques qui se dispersent dans l’air, entraînant des toxines. Le principal danger de la proximité des moisissures pour l'homme est l'inhalation de ces spores.
Comment est-ce dangereux?
La moisissure la plus commune dans la maison est noire, comme la saleté. Les autres espèces habitent le plus souvent des produits ou des textiles.
Les champignons noirs sont assez agressifs. Si vous ne les combattez pas, ils peuvent détruire la maison en transformant en poussière les planchers en bois, les planchers et les constructions en gypse.
Mais la moisissure dans l'appartement est d'abord dangereuse pour la santé des résidents. Ses spores, qui peuvent pénétrer dans le corps par inhalation, à travers la peau ou avec des produits contaminés, deviennent la cause de nombreuses maladies et sont loin d'être anodines.
En cas d'inhalation, les spores peuvent se produire:
- la rhinite;
- sinusite
- la sinusite;
- une bronchite;
- la trachéite;
- pneumonie
- aspergillose pulmonaire;
- la candidose;
- stomatite
- myocardite;
- méningite
- diminution de l'immunité;
- diathèse et allergies;
- dommages aux reins, au foie;
- maladies oncologiques.
En contact avec la peau, il est possible de:
- une dermatite;
- eczéma
- l'urticaire;
- la conjonctivite;
- mycoses (infections fongiques de la peau, puis des muscles, des os, des organes internes).
Lorsqu'ils sont ingérés, les champignons provoquent le plus souvent le botulisme - empoisonnement grave, réactions allergiques, lésions diverses du système digestif et même du sang.
Si la moisissure s'est déposée sur le produit, jetez-le complètement, qu'il s'agisse d'un pain ou d'une boîte de conserves au vinaigre. Enlever la couche supérieure ne signifie nullement se débarrasser du champignon: ses spores ont déjà pénétré jusque dans les profondeurs, jusqu'à ce qu'elles soient visibles à l'œil.
Comment se débarrasser?
Comme vous pouvez le constater, la liste des problèmes pouvant être causés par la moisissure est non seulement longue, mais loin d’être anodine. Les plus grandes menaces attendent les personnes immunodéprimées, les personnes allergiques, les asthmatiques, ainsi que les jeunes enfants dont l’immunité n’est pas encore complètement formée.Avec une bonne réponse immunitaire, le corps peut lutter contre les spores de moisissures qui y pénètrent assez longtemps. Mais aussi pas sans fin. Par conséquent, il est nécessaire de se débarrasser de ce quartier dès qu’au moins une petite épidémie est découverte.
Le champignon sur les murs est particulièrement dangereux: sur une grande surface, il se propage presque à la vitesse de l'éclair, la concentration de toxines et de spores dans l'air d'une telle pièce se développe également à la vitesse de l'éclair, ce qui augmente les risques de conséquences pour les résidents. En outre, le béton et la brique traversent le moule assez profondément, contrairement au métal, au verre ou aux carreaux, par exemple.
Les «colonies» moisies ne suffisent pas pour simplement essuyer avec une éponge. Premièrement, le champignon doit être lavé et le plus soigneusement possible de tous les revêtements, angles, joints, crevasses (jetez les objets et les objets frappés par celui-ci!). Deuxièmement, tuer ses micelles sur des surfaces avec des moyens spéciaux, troisièmement, créer des conditions inadéquates pour la propagation ultérieure de moisissures.
Alors, comment gérez-vous les habitats de moisissure après le rinçage? Tout d'abord, n'essayez pas de faire cela avec des agents bactéricides: ils sont conçus pour tuer les bactéries, et dans ce cas nous parlons d'infections fongiques. Les moyens doivent être antifongiques.
Par exemple, il est possible de traiter les surfaces affectées avec le rayonnement d'une lampe à ultraviolets, ainsi que du vinaigre, une solution de soude ou de peroxyde d'hydrogène (gardez simplement à l'esprit que ce dernier peut blanchir la couleur du revêtement).
Les murs nettoyés du papier peint ou de la peinture sont traités avec un apprêt antifongique spécial. La même chose est faite avec les coutures des carreaux.
Les carreaux, les revêtements de sol, les surfaces en verre et en miroir peuvent être économisés grâce à l’agent de blanchiment chloré ou à l’ammoniac ordinaire.
Si la pièce dans laquelle les travaux de construction et de finition sont infectés, des composés antifongiques doivent être ajoutés à tous les mélanges de construction ou de finition.
Et pour que l'attaque de la moisissure ne reprenne pas, il est nécessaire de prévoir une bonne ventilation dans les locaux et de maintenir l'humidité aussi faible que possible.
La moisissure dans un appartement ou une maison est un grave danger. Pour éviter de nuire à la santé des habitants d'un tel logement, y compris des animaux, il est important de prendre des mesures pour accélérer la destruction des colonies de moisissures. Il y a plusieurs façons de le faire: choisir le bon ne sera pas difficile. Mais il est également important de veiller constamment à ce que le microclimat des locaux ne favorise pas la réapparition d'un «voisin» non invité.